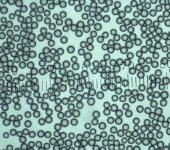
Dri-Cal 尺寸標準微粒
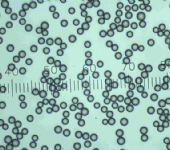
4D系列尺寸標準微粒，乾粉

- ☆ ★~歡迎您到留言版給我們加油打氣~☆ ★
- ☆ ★~歡迎光臨本站~☆ ★
尺寸標準微粒
分類名稱: 尺寸標準微粒
-

- 2000系列粒徑均一聚合物微粒 NIST溯源
- Thermo Scientific™ Duke標準品2000系列均質聚合物是NIST可溯源聚苯乙烯DVB微球,具有更寬的粒徑分佈,模擬真實世界的微粒,更適合用於激光衍射型儀器。
-

- 3000系列尺寸標準微粒, 20 至 900 nm
- Thermo Scientific™ 3000 系列 Nanosphere™ 尺寸標準微粒可便捷地檢測細菌、病毒、核醣體和亞細胞成分的大小,非常適合於需要具有極窄標準偏差的 NIST™ 溯源性尺寸標準品的領域。 20 – 900 nm 的納米球範圍是電子和原子力顯微鏡校準的理想選擇。此標準品也可用於激光散射研究和膠體系統研究。
-

- 4000系列尺寸標準微粒 1um至1mm
- Thermo Scientific™ 4000 系列單一尺寸微粒可使分析系統對形狀影響的反應最小化,非常適合於需要具有極窄標準偏差的 NIST™ 溯源性尺寸標準品的領域。
-

- 8000系列二氧化矽標準微球
- Thermo Scientific™ 8000 系列二氧化矽尺寸標準微球是一種可以用於儀器校準和用作間隔劑的單分散二氧化矽微球,使用包含這種粒子的溶液可以獲得更高的持久性和化學穩定性。這類產品經校準並獲得平均直徑具有 NIST 溯源的認證證書,廣泛適用於微粒測定領域。
-

- 9000系列玻璃標準微粒
- Thermo Scientific™ 9000 系列玻璃微粒標準品是一種具有 NIST™ 溯源認證證書的干燥型玻璃尺寸標準品,可以替代許多應用中的聚苯乙烯微球。該玻璃微球可適用於任何一種需要使用 NIST™ 可溯源尺寸標準品且微粒分佈範圍窄的應用領域,這些領域不適於採用聚苯乙烯微球。除了具有更高的機械和熱穩定性外,玻璃微球對化學製劑和溶劑也具有更好的耐受性。
-

- Chromosphere-T 認證的尺寸標準微粒
- Thermo Scientific™ ChromoSphere™-T 認證的尺寸標準微粒是彩色的聚合物微球,能獲得非常高的視覺對比度,其直徑通過 NIST™ 可溯源至標準度量值。這些參照和校準材料適用於過濾系統測試、試劑瓶清潔度評估、污染控制檢查以及注射設備校準。
-

- Surf-Cal 尺寸標準微粒
- Surf-Cal 尺寸標準微粒用於半導體工業的掃描表面監測系統(SISS)的校準,滿足SEMI 標準規則要求。所提供的微粒尺寸包括半導體國際技術藍圖 (ITRS)定義的關鍵的尺寸節點的大小。Surf-Cal標準品可用來簡化您工廠內校準晶片的準備工作。可提供的微粒尺寸與儀器生產商要求的校準點大小一致。
-
- Dri-Cal 尺寸標準微粒
- Thermo Scientific™ Dri-Cal™ 微粒尺寸標準品主要用來校準微粒大小分析與計數的儀器,而且是需要乾粉微粒的儀器。
-
- 4D系列尺寸標準微粒,乾粉
- Thermo Scientific™ 4D 系列乾粉微球尺寸標準品可用於校準空氣微粒計數儀 (OPC),使之符合 ISO 21501-4 法規。這些微球參考粒子的校準不確定度(實際平均直徑的值範圍)小於或等於平均直徑的 2.5%,是儀器生產商和製藥、生物技術與電子設備製造 QA/QC 經理的理想選擇。



.png)
.png)






.png)









